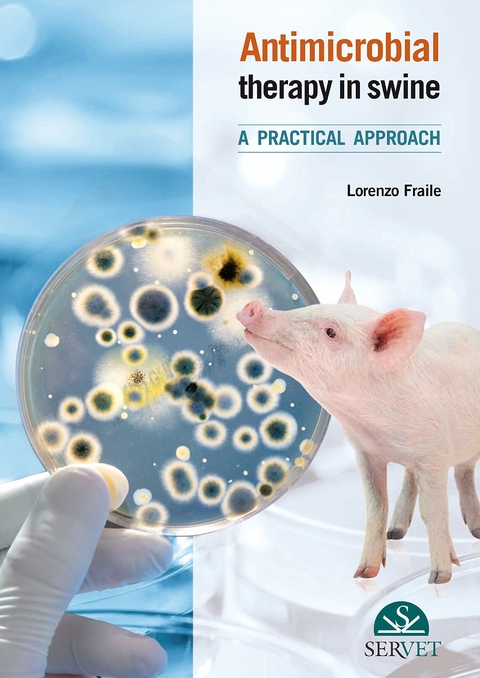
Antimicrobial Therapy in swine - Lorenzo José Fraile Sauce

Antimicrobial Therapy in swine
A practical approach
Seiten
2013
Servet Publishing (Verlag)
978-84-941014-9-6 (ISBN)
Servet Publishing (Verlag)
978-84-941014-9-6 (ISBN)
- Titel ist leider vergriffen;
keine Neuauflage - Artikel merken
In this book on practical antibiotherapy in swine medicine, the author has tried to present, in a visual and practical way and with an updated view, the most important aspects a veterinary clinician should take into account to design appropriate antimicrobial treatments in swine herds. Thus, in this work, the current pharmacological knowledge is reviewed with the help of real clinical cases solved by the author. Finally, it includes a comprehensive review of what a prudent use of these essential tools to ensure our animals’ health means.
| Erscheint lt. Verlag | 1.1.2013 |
|---|---|
| Verlagsort | Zaragosa / Spanien |
| Sprache | englisch |
| Maße | 170 x 240 mm |
| Gewicht | 760 g |
| Einbandart | gebunden |
| Themenwelt | Veterinärmedizin ► Allgemein ► Tierernährung / Tierhaltung / Tierzucht |
| Veterinärmedizin ► Klinische Fächer | |
| Veterinärmedizin ► Großtier ► Schwein | |
| Schlagworte | Schwein; Veterinärmedizin |
| ISBN-10 | 84-941014-9-8 / 8494101498 |
| ISBN-13 | 978-84-941014-9-6 / 9788494101496 |
| Zustand | Neuware |
| Informationen gemäß Produktsicherheitsverordnung (GPSR) | |
| Haben Sie eine Frage zum Produkt? |
Mehr entdecken
aus dem Bereich
aus dem Bereich
Grundlagen - Fütterung - Diätetik Begründet von Helmut Meyer
Buch (2022)
Thieme (Verlag)
CHF 106,90
Praxisleitfaden für eine tiergerechte Hühnerhaltung
Buch | Softcover (2023)
Landwirtschaftsverlag Münster
CHF 64,40


